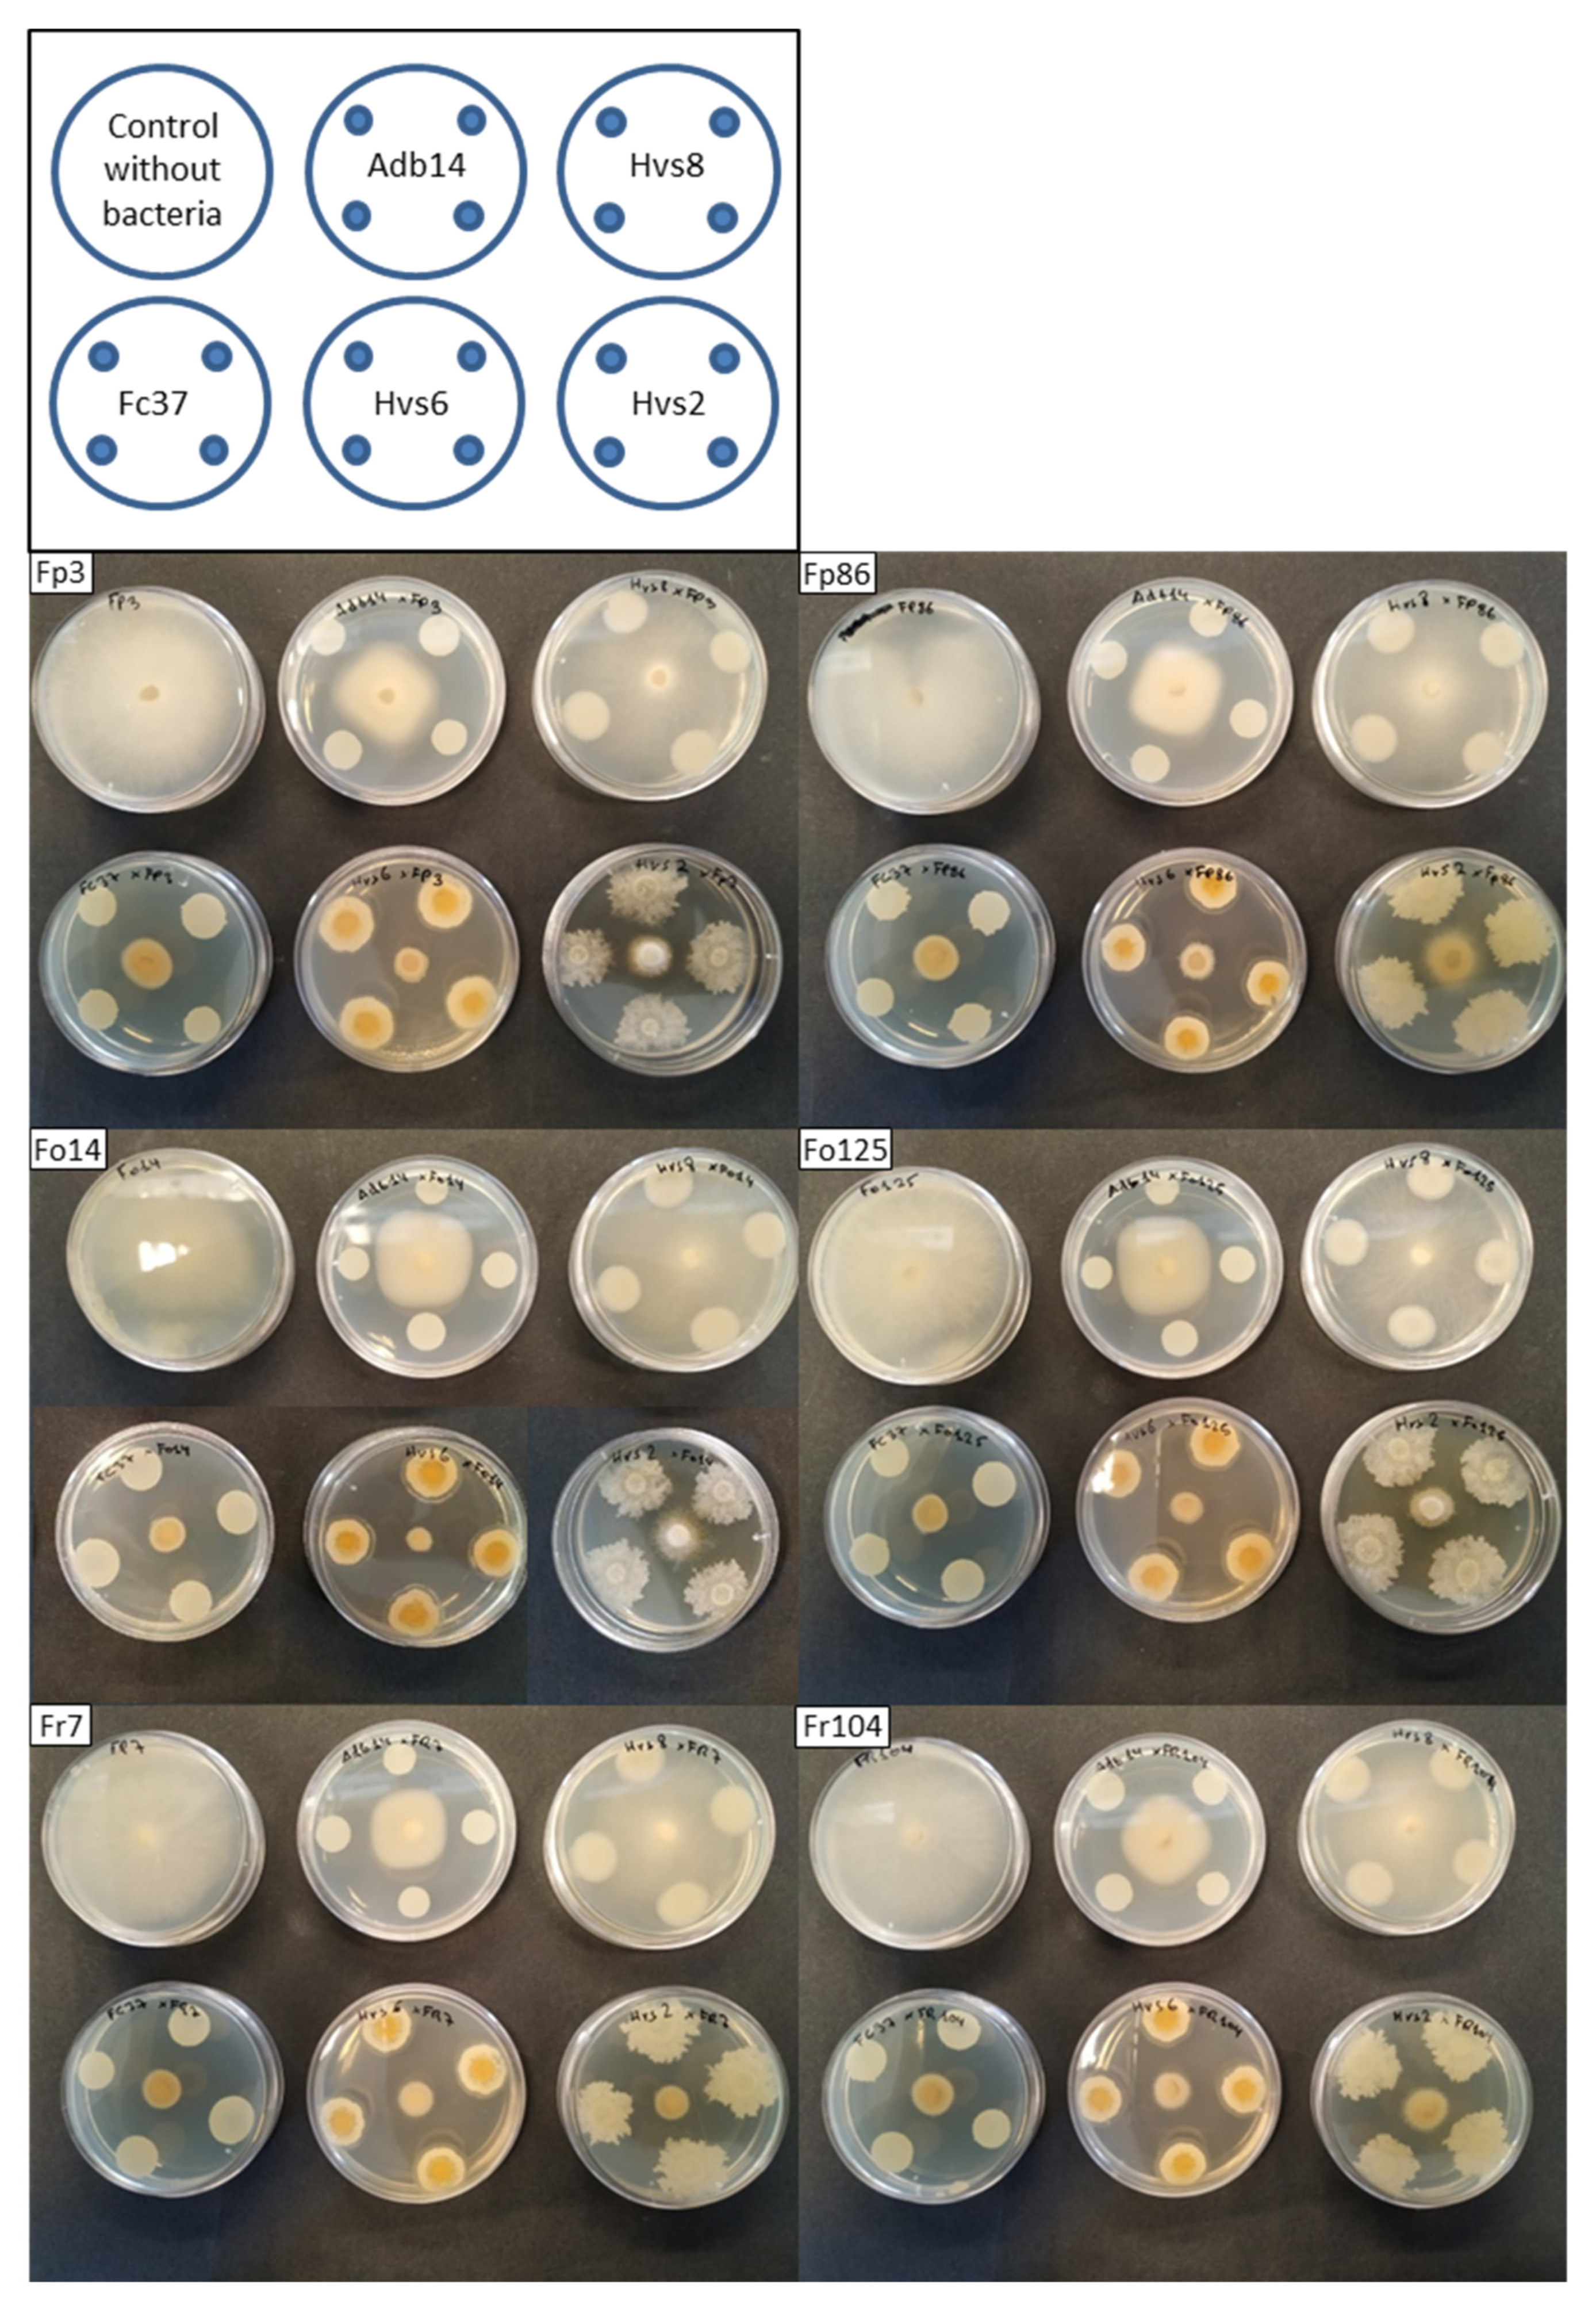
Applsci 11 08356 g002 Applsci 11 08356 g002

Soil Bacteria as Potential Biological Control Agents of Fusarium Species Associated with Asparagus Decline Syndrome
Abstract
Featured Application
Abstract
1. Introduction
2. Materials and Methods
2.1. Fungal Isolates
2.2. Bacterial Strains
2.3. Dual Plate Confrontation Experiments
2.4. Growth Chamber Experiments
2.5. Disease Assessments
2.6. Enzymatic Activity of Bacterial Strains
2.7. Production of Plant Growth-Promoting Compounds
2.8. Data Analysis
3. Results
3.1. Antagonism In Vitro
3.2. Biological Control of Fusarium Species in Growth Chamber Conditions
3.3. Biocontrol Enzymatic Activity of Bacterial Strains
3.4. Production of Plant Growth-Promoting Compounds
4. Discussion
5. Conclusions
Supplementary Materials
Author Contributions
Funding
Institutional Review Board Statement
Informed Consent Statement
Data Availability Statement
Conflicts of Interest
References
- Rodríguez, R.; Jaramillo, S.; Rodríguez, G.; Espejo, J.A.; Guillén, R.; Fernández-Bolaños, J.; Heredia, A.; Jiménez, A. Antioxidant activity of ethanolic extracts from several asparagus cultivars. J. Agric. Food Chem. 2005, 53, 5212–5217. [Google Scholar] [CrossRef] [PubMed]
- Lee, J.W.; Lee, J.H.; Yu, I.H.; Gorinstein, S.; Bae, J.H.; Ku, Y.G. Bioactive compounds, antioxidant and binding activities and spear yield of Asparagus officinalis L. Plant Foods Hum. Nutr. 2014, 9, 175–181. [Google Scholar] [CrossRef] [PubMed]
- Elmer, W.H. Fusarium diseases of asparagus. In Fusarium: Paul E. Nelson Memorial Symposium; Summerell, B.A., Leslie, J.F., Backhouse, D., Bryden, W.L., Burgess, L.W., Eds.; American Phytopathological Society Press: St. Paul, MN, USA, 2001; pp. 248–262. [Google Scholar]
- Blok, W.J.; Bollen, G.J. The role of autotoxins from root residues of the previous crop in the replant disease of asparagus. Neth. J. Plant Pathol. 1993, 99, 29–40. [Google Scholar] [CrossRef]
- Elmer, W. Asparagus decline and replant problem: A look back and a look forward at strategies for mitigating losses. Acta Hortic. 2018, 1223, 195–204. [Google Scholar] [CrossRef]
- Brizuela, A.M.; De la Lastra, E.; Marín-Guirao, J.I.; Gálvez, L.; de Cara-García, M.; Capote, N.; Palmero, D. Fusarium consortium populations associated with asparagus crop in Spain and their role on field decline syndrome. J. Fungi 2020, 6, 336. [Google Scholar] [CrossRef]
- De la Lastra, E.; Marín-Guirao, J.I.; López-Moreno, F.J.; De Cara, M.; Soriano, T.; Capote, N. Especies de Fusarium relacionadas con el síndrome del decaimiento del espárrago en Andalucía. Phytoma 2020, 324, 2–9. [Google Scholar]
- Corpas-Hervias, C.; Melero-Vara, J.M.; Molinero-Ruiz, M.L.; Zurera-Muñoz, C.; Basallote-Ureba, M.J. Characterization of isolates of Fusarium spp. obtained from asparagus in Spain. Plant Dis. 2006, 90, 1441–1451. [Google Scholar] [CrossRef]
- De la Lastra, E.; Marín-Guirao, J.I.; López-Moreno, F.J.; Soriano, T.; de Cara-García, M.; Capote, N. Potential inoculum sources of Fusarium species involved in asparagus decline syndrome and evaluation of soil disinfestation methods by qPCR protocols. Pest Manag. Sci. 2021, in press. [Google Scholar] [CrossRef]
- Liu, J.; Matsubara, Y. Induced systemic resistance to Fusarium root rot and changes in antioxidative ability by arbuscular mycorrhizal fungus and non-pathogenic Fusarium oxysporum in Asparagus Plants. J. Jpn. Soc. Agric. Technol. Manag. 2016, 23, 21–29. [Google Scholar] [CrossRef]
- Elmer, W.H. Combining nonpathogenic strains of Fusarium oxysporum with sodium chloride to suppress Fusarium crown rot of asparagus in replanted fields. Plant Pathol. 2004, 53, 751–758. [Google Scholar] [CrossRef]
- Haque, S.I.; Matsubara, Y. Arbuscular-mycorrhiza-induced salt tolerance and resistance to Fusarium root rot in asparagus plants. Acta Hortic. 2018, 1227, 365–372. [Google Scholar] [CrossRef]
- Arriola, L.; Hausbeck, M.; Rogers, J.; Safir, G. The effect of Trichoderma harzianum and arbuscular mycorrhizae on Fusarium root rot in asparagus. HortTechnology 2000, 10, 141–144. [Google Scholar] [CrossRef]
- Surono; Narisawa, K. The inhibitory role of dark septate endophytic fungus Phialocephala fortinii against Fusarium disease on the Asparagus officinalis growth in organic source conditions. Biol. Control 2018, 121, 159–167. [Google Scholar] [CrossRef]
- Rubio-Pérez, E.; Molinero-Ruiz, M.L.; Melero-Vara, J.M.; Basallote-Ureba, M.J. Selection of potential antagonists against asparagus crown and root rot caused by Fusarium spp. Commun. Agric. Appl. Biol. Sci. 2008, 73, 203–206. Available online: https://pubmed.ncbi.nlm.nih.gov/19226757/ (accessed on 31 August 2021).
- Smith, J.; Putnam, A.; Nair, M. In vitro control of Fusarium diseases of Asparagus-officinalis L. with a Streptomyces or its polyene antibiotic, faeriefungin. J. Agric. Food Chem. 1990, 38, 1729–1733. [Google Scholar] [CrossRef]
- Elmer, W.H. Association between Mn-reducing root bacteria and NaCl applications in suppression of Fusarium crown and root rot of asparagus. Phytopathology 1995, 85, 1461–1467. [Google Scholar] [CrossRef]
- Godfrey, S.A.C.; Silby, M.W.; Falloon, P.G.; Mahanty, H.K. Biological control of Phytophthora megasperma var. sojae, causal agent of Phytophthora rot of asparagus, by Pseudomonas aureofaciens PA147-2: A preliminary field trial. N. Z. J. Crop Hortic. Sci. 2000, 28, 97–103. [Google Scholar] [CrossRef][Green Version]
- Khan, N.; Martínez-Hidalgo, P.; Ice, T.A.; Maymon, M.; Humm, E.A.; Nejat, N.; Sanders, E.R.; Kaplan, D.; Hirsch, A.M. Antifungal activity of Bacillus species against Fusarium and analysis of the potential mechanisms used in biocontrol. Front. Microbiol. 2018, 9, 2363. [Google Scholar] [CrossRef]
- Kashyap, B.K.; Solanki, M.K.; Pandey, A.K.; Prabha, S.; Kumar, P.; Kumari, B. Bacillus as Plant Growth Promoting Rhizobacteria (PGPR): A promising green agriculture technology. In Plant Health Under Biotic Stress; Ansari, R., Mahmood, I., Eds.; Springer: Singapore, 2019. [Google Scholar] [CrossRef]
- Goswami, D.; Thakker, J.N.; Dhandhukia, P.C. Portraying mechanics of plant growth promoting rhizobacteria (PGPR): A review. Cogent Food Agric. 2016, 2, 1127500. [Google Scholar] [CrossRef]
- Liu, K.; McInroy, J.A.; Hu, C.H.; Kloepper, J.W. Mixtures of plant-growth-promoting rhizobacteria enhance biological control of multiple plant diseases and plant-growth promotion in the presence of pathogens. Plant Dis. 2018, 102, 67–72. [Google Scholar] [CrossRef]
- Hoagland, D.; Arnon, D.I. The Water-Culture Method for Growing Plants without Soil, 2nd ed.; Circular 347; University of California Agricultural Experiment Station: Berkeley, CA, USA, 1950; p. 32. [Google Scholar]
- Leslie, J.F.; Summerell, B.A. The Fusarium Laboratory Manual; Blackwell: Ames, IA, USA, 2006; p. 388. [Google Scholar]
- Nelson, P.E.; Tousson, T.A.; Marasas, W.F.O. Fusarium Species: An Illustrated Manual for Identification; The Pennsylvania State University Press: University Park, PA, USA, 1983. [Google Scholar]
- Mesa, J.; Mateos-Naranjo, E.; Caviedes, M.A.; Redondo-Gómez, S.; Pajuelo, E.; Rodríguez-Llorente, I.D. Endophytic cultivable bacteria of the metal bioaccumulator Spartina maritima improve plant growth but not metal uptake in polluted marshes soils. Front. Microbiol. 2015, 6, 1450. [Google Scholar] [CrossRef]
- Gong, X.; Gruninger, R.J.; Qi, M.; Paterson, L.; Forster, R.J.; Teather, R.M.; Mcallister, T.A. Cloning and identification of novel hydrolase genes from a dairy cow rumen metagenomic library and characterization of a cellulase gene. BMC Res. Notes 2012, 5, 566. [Google Scholar] [CrossRef]
- Bano, N.; Musarrat, J. Characterization of a new Pseudomonas aeruginosa strain NJ-15 as a potential biocontrol agent. Curr. Microbiol. 2003, 46, 324–328. [Google Scholar] [CrossRef]
- Pacheco-Hernández, X.J.; Rodríguez-Dorantes, A.; González-Rivera, R.; Amora-Lazcano, E.; Guerrero-Zúñiga, L.A.; Rodríguez-Tovar, A.V. Evaluación del efecto fitotóxico de rizobacterias deletéreas sobre el crecimiento radical de Axonopus affinis (Chase) y Lens esculenta (Moench). Polibotánica 2015, 40, 137–152. [Google Scholar] [CrossRef]
- Reetha, A.K.; Pavani, S.L.; Mohan, S. Hydrogen cyanide production ability by bacterial antagonist and their antibiotics inhibition potential on Macrophomina phaseolina (Tassi.) Goid. Int. J. Curr. Microbiol. Appl. Sci. 2014, 3, 172–178. [Google Scholar]
- Benizri, E.; Courtade, A.; Picard, C.; Guckert, A. Role of maize root exudates in the production of auxins by Pseudomonas fluorescens M.3.1. Soil Biol. Biochem. 1998, 30, 1481–1484. [Google Scholar] [CrossRef]
- Alexander, D.B.; Zuberer, D.A. Use of chrome azurol S reagents to evaluate siderophore production by rhizosphere bacteria. Biol. Fertil. Soils 1991, 12, 39–45. [Google Scholar] [CrossRef]
- De Freitas, J.R.; Banerjee, M.R.; Germida, J.J. Phosphate-solubilizing rhizobacteria enhance the growth and yield but not phosphorous uptake of canola (Brassica napus L.). Biol. Fertil. Soils 1997, 24, 358–364. [Google Scholar] [CrossRef]
- Pastrana, A.; Basallote-Ureba, M.; Aguado, A.; Akdi, K.; Capote, N. Biological control of strawberry soil-borne pathogens Macrophomina phaseolina and Fusarium solani, using Trichoderma asperellum and Bacillus spp. Phytopathol. Mediterr. 2016, 55, 109–120. [Google Scholar] [CrossRef]
- Abdel-Gayed, M.A.; Abo-Zaid, G.A.; Matar, S.M.; Hafez, E.E. Fermentation, formulation and evaluation of PGPR Bacillus subtilis isolate as a bioagent for reducing occurrence of peanut soil-borne diseases. J. Integr. Agric. 2019, 18, 2080–2092. [Google Scholar] [CrossRef]
- Viejobueno, J.; Albornoz, P.L.; Camacho, M.; de los Santos, B.; Martínez-Zamora, M.G.; Salazar, S.M. Protection of strawberry plants against Charcoal rot disease (Macrophomina phaseolina) induced by Azospirillum brasilense. Agronomy 2021, 11, 195. [Google Scholar] [CrossRef]
- Bubici, G. Streptomyces spp. as biocontrol agents against Fusarium species. CAB Rev. 2018, 13, 50. [Google Scholar] [CrossRef]
- Abed, H.; Rouag, N.; Mouatassem, D.; Rouabhi, A. Screening for Pseudomonas and Bacillus antagonistic rhizobacteria strains for the biocontrol of Fusarium wilt of chickpea. Eurasian J. Soil Sci. 2016, 5, 182–191. [Google Scholar] [CrossRef]
- Camacho, M.; Aparicio, L.; Perez-Carmona, C.; de los Santos, B. Empleo de bacterias rizosféricas como sustitutas de productos químicos de síntesis para un cultivo sostenible de la fresa (Fragaria x ananassa Duch.). Actas Hortic. (Febrero) 2017, 459–466, ISBN 978-84-697-6628-6. [Google Scholar]
- Wang, C.; Zhao, D.; Qi, G.; Mao, Z.; Hu, X.; Du, B.; Liu, K.; Ding, Y. Effects of Bacillus velezensis FKM10 for promoting the growth of Malus hupehensis Rehd. and inhibiting Fusarium verticillioides. Front. Microbiol. 2020, 10, 2889. [Google Scholar] [CrossRef]
- Beneduzi, A.; Ambrosini, A.; Passaglia, L.M. Plant growth-promoting rhizobacteria (PGPR): Their potential as antagonists and biocontrol agents. Genet. Mol. Biol. 2012, 35, 1044–1051. [Google Scholar] [CrossRef] [PubMed]
- Blake, C.; Christensen, M.N.; Kovács, Á.T. Molecular aspects of plant growth promotion and protection by Bacillus subtilis. Mol. Plant-Microbe Interact. 2021, 34, 15–25. [Google Scholar] [CrossRef]
- Gorai, P.S.; Ghosh, R.; Konra, S.; Mandal, N.C. Biological control of early blight disease of potato caused by Alternaria alternata EBP3 by an endophytic bacterial strain Bacillus velezensis SEB1. Biol. Control 2021, 156, 104551. [Google Scholar] [CrossRef]
- Myo, E.M.; Liu, B.; Ma, J.; Shi, L.; Jiang, M.; Zhang, K.; Ge, B. Evaluation of Bacillus velezensis NKG-2 for bio-control activities against fungal diseases and potential plant growth promotion. Biol. Control 2019, 134, 23–31. [Google Scholar] [CrossRef]
- Kirimura, K.; Hirowatari, Y.; Usami, S. Alterations of respiratory systems in Aspergillus niger under the conditions of citric acid fermentation. Agric. Biol. Chem. 1987, 51, 1299–1303. [Google Scholar] [CrossRef]
- O’Donnell, K.; Gueidan, C.; Sink, S.; Johnston, P.R.; Crous, P.W.; Glenn, A.; Riley, R.; Zitomer, N.C.; Colyer, P.; Waalwijk, C.; et al. A two-locus DNA sequence database for typing plant and human pathogens within the Fusarium oxysporum species complex. Fungal Genet. Biol. 2009, 46, 936–948. [Google Scholar] [CrossRef]
- Noperi-Mosqueda, L.C.; López-Moreno, F.J.; Navarro-León, E.; Sánchez, E.; Blasco, B.; Moreno, D.A.; Soriano, T.; Ruiz, J.M. Effects of asparagus decline on nutrients and phenolic compounds, spear quality, and allelopathy. Sci. Hortic. 2020, 261, 109029. [Google Scholar] [CrossRef]
- Ellermann, M.; Arthur, J.C. Siderophore-mediated iron acquisition and modulation of host-bacterial interactions. Free Radic. Biol. Med. 2017, 105, 68–78. [Google Scholar] [CrossRef] [PubMed]
- Williams, K.M.; Martin, W.E.; Smith, J.; Williams, B.S.; Garner, B.L. Production of protocatechuic acid in Bacillus thuringiensis ATCC33679. Int. J. Mol. Sci. 2012, 13, 3765. [Google Scholar] [CrossRef]
- Besset-Manzoni, Y.; Joly, P.; Brutel, A.; Gerin, F.; Soudière, O.; Langin, T.; Prigent-Combaret, C. Does in vitro selection of biocontrol agents guarantee success in planta? A study case of wheat protection against Fusarium seedling blight by soil bacteria. PLoS ONE 2019, 14, e0225655. [Google Scholar] [CrossRef] [PubMed]

| Fungus-Bacteria Coinoculations | Dead Plants (%) | Root Fresh Weight (g) | Shoot Fresh Weight (g) | Root Severity | Shoot Severity | AUDPC |
|---|---|---|---|---|---|---|
| FC37 | 0 | 0.92 ± 0.43 | 0.20 ± 0.06 | 0.1 ± 0.3 | 0.7 ± 0.5 | 0.3 ± 0.4 |
| Hvs2 | 0 | 0.79 ± 0.23 | 0.20 ± 0.05 | 0.1 ± 0.3 | 0.8 ± 0.8 | 0.2 ± 0.3 |
| Hvs6 | 0 | 0.77 ± 0.22 | 0.20 ± 0.04 | 0.0 ± 0.0 | 0.8 ± 1.0 | 0.3 ± 0.5 |
| Non-inoculated | 0 | 0.73 ± 0.42 | 0.21 ± 0.08 | 0.1 ± 0.3 | 0.2 ± 0.4 | 0.0 ± 0.0 |
| Fp3-FC37 | 33 | 0.11 ± 0.09 a | 0.07 ± 0.04 a | 2.6 ± 1.1 | 3.3 ± 1.5 | 2.3 ± 1.3 |
| Fp3-Hvs2 | 58 | 0.08 ± 0.05 ab | 0.05 ± 0.03 ab | 2.6 ± 0.9 | 4.3 ± 1.1 | 2.9 ± 1.1 |
| Fp3-Hvs6 | 67 | 0.04 ± 0.05 b | 0.02 ± 0.02 b | 3.2 ± 1.0 | 3.9 ± 1.9 | 2.7 ± 1.4 |
| Fp3 | 78 | 0.04 ± 0.04 b | 0.05 ± 0.04 ab | 2.9 ± 0.6 | 4.1 ± 1.8 | 3.3 ± 1.4 |
| Fp86-FC37 | 33 | 0.20 ± 0.19 a | 0.08 ± 0.05 a | 2.6 ± 0.9 | 3.3 ± 1.7 | 1.7 ± 1.0 |
| Fp86-Hvs2 | 33 | 0.14 ± 0.11 ab | 0.08 ± 0.05 a | 2.6 ± 0.8 | 3.4 ± 1.4 | 2.0 ± 1.1 |
| Fp86 Hvs6 | 44 | 0.12 ± 0.14 ab | 0.07 ± 0.06 a | 3.0 ± 1.2 | 3.3 ± 1.9 | 2.3 ± 1.8 |
| Fp86 | 89 | 0.03 ± 0.01 b | 0.02 ± 0.01 b | 3.4 ± 0.5 | 4.7 ± 1.1 | 3.2 ± 0.8 |
| Fo125-FC37 | 25 | 0.26 ± 0.10 a | 0.11 ± 0.05 a | 2.2 ± 1.0 | 2.7 ± 1.8 | 1.5 ± 1.2 |
| Fo125-Hvs2 | 42 | 0.10 ± 0.04 b | 0.07 ± 0.04 ab | 3.0 ± 0.6 | 3.3 ± 1.7 | 2.3 ± 1.3 |
| Fo125-Hvs6 | 67 | 0.06 ± 0.08 b | 0.05 ± 0.06 b | 3.3 ± 1.1 | 4.2 ± 1.4 | 2.7 ± 1.0 |
| Fo125 | 33 | 0.12 ± 0.08 b | 0.06 ± 0.03 b | 2.2 ± 1.2 | 2.8 ± 1.9 | 1.9 ± 1.6 |
| Fo14 -FC37 | 0 | 0.79 ± 0.21 a | 0.19 ± 0.05 a | 0.5 ± 0.5 | 0.9 ± 0.5 | 0.2 ± 0.2 |
| Fo14-Hvs2 | 0 | 0.67 ± 0.18 ab | 0.16 ± 0.04 a | 0.7 ± 0.5 | 0.5 ± 0.5 | 0.3 ± 0.4 |
| Fo14-Hvs6 | 0 | 0.69 ± 0.16 ab | 0.18 ± 0.04 a | 0.8 ± 0.4 | 0.9 ± 1.1 | 0.4 ± 0.7 |
| Fo14 | 0 | 0.53 ± 0.12 b | 0.15 ± 0.05 a | 0.7 ± 0.5 | 0.7 ± 1.0 | 0.3 ± 0.4 |
| Bacterial Strain | Siderophore | Phosphate Solubilization | Auxin |
|---|---|---|---|
| Adb14 | + | - | - |
| FC37 | - | + | - |
| Hvs2 | - | - | - |
| Hvs6 | +++ | - | - |
| Hvs8 | - | - | + |
Publisher’s Note: MDPI stays neutral with regard to jurisdictional claims in published maps and institutional affiliations. |
© 2021 by the authors. Licensee MDPI, Basel, Switzerland. This article is an open access article distributed under the terms and conditions of the Creative Commons Attribution (CC BY) license (https://creativecommons.org/licenses/by/4.0/).
Share and Cite
De la Lastra, E.; Camacho, M.; Capote, N. Soil Bacteria as Potential Biological Control Agents of Fusarium Species Associated with Asparagus Decline Syndrome. Appl. Sci. 2021, 11, 8356. https://doi.org/10.3390/app11188356
De la Lastra E, Camacho M, Capote N. Soil Bacteria as Potential Biological Control Agents of Fusarium Species Associated with Asparagus Decline Syndrome. Applied Sciences. 2021; 11(18):8356. https://doi.org/10.3390/app11188356
Chicago/Turabian StyleDe la Lastra, Eduardo, María Camacho, and Nieves Capote. 2021. "Soil Bacteria as Potential Biological Control Agents of Fusarium Species Associated with Asparagus Decline Syndrome" Applied Sciences 11, no. 18: 8356. https://doi.org/10.3390/app11188356
APA StyleDe la Lastra, E., Camacho, M., & Capote, N. (2021). Soil Bacteria as Potential Biological Control Agents of Fusarium Species Associated with Asparagus Decline Syndrome. Applied Sciences, 11(18), 8356. https://doi.org/10.3390/app11188356

